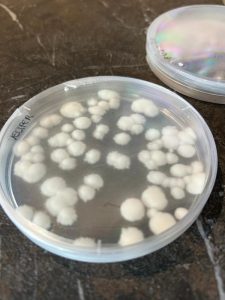
Placa con Velifer

La agricultura regenerativa, el papel del microbioma y la necesidad de nuevas herramientas biológicas marcaron la jornada técnica “Integración de insecticidas microbianos en programas de tratamiento con prebióticos”, celebrada el pasado 6 de noviembre en el restaurante La Costa (El Ejido, Almería). El encuentro,, organizado por Viagro y BASF, reunió a técnicos y productores para profundizar en los retos actuales de control de plagas y en cómo las biosoluciones pueden responder a ellos.
Evolución del Vademécum y digitalización del sector
Carlos de Liñán, director de Portal Tecnoagrícola, abrió la jornada haciendo un recorrido por la historia del Vademécum, nacido en 1980 como respuesta a la necesidad de ofrecer información objetiva y completa sobre los insumos disponibles en el mercado.
Como explicó, la herramienta ha evolucionado hacia un sistema digital en continua actualización, en el que se puede encontrar información técnica actualizada y contrastada sobre productos fitosanitarios, nutricionales, bioestimulantes y semillas. Lo más novedoso, dijo, es su nueva sección específica de agricultura regenerativa, donde los insumos se clasifican en tres grupos: autorizados, regeneradores y prebióticos.
La actualización ya incorpora los resultados de las evaluaciones realizadas por el consorcio científico Food for Sustainable Future y responde al cambio que ha ido sufriendo el sector hortofrutícola a lo largo de estos más de 40 años de vida del Vademécum. “Cuando empezó mi padre, prácticamente dos terceras partes de los productos eran fitosanitarios. Y eso ha evolucionado a que los fitosanitarios son como unos 1.000 productos de los 8.000 que hay ahora mismo en el Vademécum”, apuntó Carlos de Liñán.
La próxima novedad llegará entre finales de año y principios de 2026, con la suma de una herramienta para poder integrar información al cuaderno de campo digital, que será obligatorio en enero de 2027.
Medir el impacto de los insumos en el microbioma
La segunda intervención corrió a cargo de Mercedes Tirado, coordinadora de la plataforma Food for Sustainable Future. La investigadora expuso los fundamentos científicos que sustentan la acreditación para agricultura regenerativa y detalló los protocolos utilizados para evaluar el comportamiento de los insumos sobre el microbioma del suelo y la planta.
Entre las conclusiones, Tirado destacó la importancia de diferenciar entre los efectos de cada tipo de producto y la necesidad de validar, mediante ensayos de campo e in vitro, su compatibilidad con microorganismos nativos.
Durante su exposición mostró ejemplos de placas microbiológicas donde microorganismos autóctonos (hongos del género Penicillium, Beauveria, Bacillus, entre otros) demostraban su efecto de control frente a patógenos como Fusarium o Sclerotinia.
También subrayó cómo los prebióticos pueden incrementar las unidades formadoras de colonia de microorganismos benéficos (como ocurría al aplicar REKO® junto a Velifer®), reforzando así la capacidad natural del cultivo para defenderse.
Velifer®: bioinsecticida de última generación
El delegado técnico comercial de BASF, Óscar Barbero, centró su intervención en Velifer®, el primer bioinsecticida que incorporaron al catálogo de soluciones de la compañía y el primero también en ser autorizado en agricultura regenerativa.
Barbero contextualizó la creciente presión de plagas (mosca blanca, trips y tuta), agravada por el cambio climático, la globalización y la reducción de materias activas disponibles. “Las densidades de población son incontrolables y aparecen plagas en todos lados”, afirmó. La reducción de materias activas autorizadas y la creciente exigencia por parte de la food value change conllevan una mayor necesidad de nuevas herramientas sostenibles, apuntó.
NOTICIA RELACIONADA: BASF comienza una nueva era con el Bio-insecticida Velifer®
Velifer® está elaborado con una cepa exclusiva, PPRI 15339, de Beauveria bassiana, y tiene una elevada eficacia comparativa. Está registrada para un gran número de cultivos de invernadero (tomate, pimiento, pepino, calabacín, melón, sandía y calabaza).
Barbero detalló algunos de sus principales aspectos técnicos: está formulada en una dispersión oleosa, actúa entre 0 y 6 horas, con dosis únicas de 50 ml/100 L y 73 aplicaciones autorizadas, sin riesgo de resistencias (se puede aplicar por registro cada 5 días), así como una excelente compatibilidad con la fauna auxiliar.
Además, Barbero presentó también resultados de ensayos realizados en Trips Parvispinus, donde Velifer® mostró eficacias de hasta el 93% en determinadas combinaciones y condiciones controladas.
Reko®: el papel de los prebióticos en la activación del microbioma
El cierre del acto lo protagonizó Francisco Javier del Águila, director de Viagro, quien expuso el funcionamiento de REKO®, un prebiótico capaz de activar microorganismos nativos del cultivo y potenciar la eficacia de herramientas microbianas como Velifer®.
Del Águila recalcó que la palabra ‘prebiótico’ suele interpretarse como un producto preventivo, cuando en realidad es “la llave que desencadena” la actividad microbiológica beneficiosa. Explicó que factores como la calidad del agua, la salinidad, las mezclas o la humedad pueden modificar de forma decisiva la expresión genética de los microorganismos, y que por ello es esencial comprender cómo interactúan insumos, cultivo y ambiente.
Como ejemplo, mostró placas donde la adición de REKO® multiplicaba la presencia de Beauveria respecto a la aplicación únicamente del bioinsecticida, logrando controles superiores de trips y mosca blanca en ensayos de campo.
La jornada dejó un mensaje claro: la protección vegetal del futuro se apoyará en biosoluciones validadas científicamente, en la comprensión del microbioma y en la integración de insecticidas microbianos con herramientas que potencien su eficacia. Velifer® y REKO® se presentaron así como ejemplos prácticos de cómo avanzar hacia modelos productivos más sostenibles, eficientes y alineados con las nuevas exigencias del mercado.
Ver esta publicación en Instagram
Una publicación compartida de Revista Fruit Today (@revistafruittoday)























































